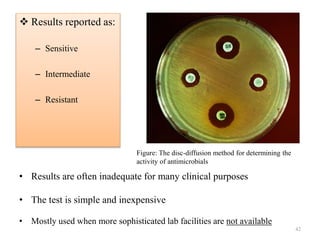
 Results reported as:
– Sensitive
– Intermediate
– Resistant
42
Figure: The disc-diffusion method for determining the
activity of antimicrobials
• Results are often inadequate for many clinical purposes
• The test is simple and inexpensive
• Mostly used when more sophisticated lab facilities are not available

The document discusses the production of antibiotics and antitumor agents through industrial microbiology. It defines antibiotics as substances produced by microorganisms that inhibit or kill other microorganisms. Antibiotics are produced through the fermentation of microorganisms like Streptomyces. The production process involves growing the culture in large tanks, isolating the antibiotic, and purifying it into final products through various chemical processes. Quality control ensures antibiotics meet standards before distribution. Some antibiotics like anthracyclines also have antitumor properties and are used to treat cancer.